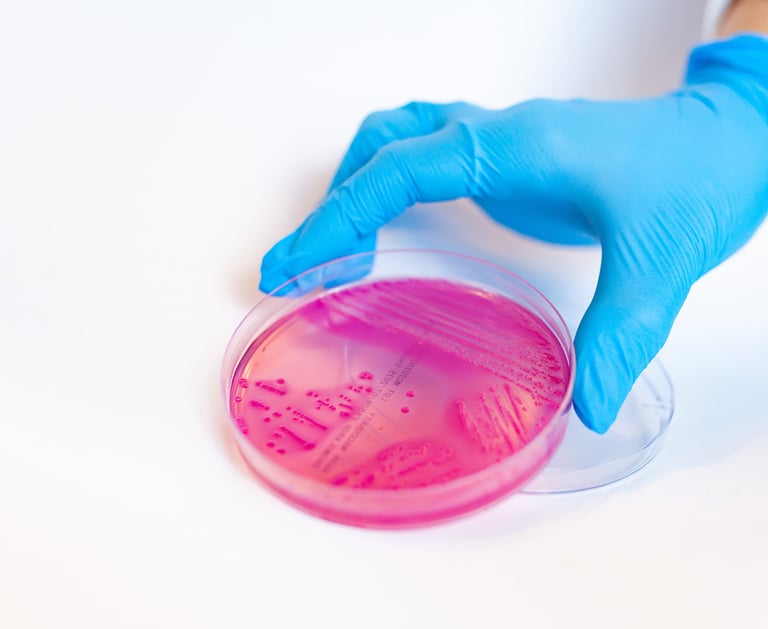

Qualidade
Descubra nossos projetos inovadores na fabricação de insumos para microbiologia.


Controle de Qualidade
Conheça nossa expertise na preparação de meios de cultura para o crescimento de microrganismos.
Segurança
Saiba mais sobre nossos produtos essenciais para o desenvolvimento de fungos e bactérias.
Certificações
Saiba mais sobre nossos produtos essenciais para o desenvolvimento de fungos e bactérias.





Os meios de cultura da Cromolabor são essenciais para o crescimento de microrganismos. Excelente qualidade!
Ana Silva
A Cromolabor fornece insumos de alta qualidade para microbiologia. Recomendo a todos!
Pedro Santos
★★★★★
★★★★★
Experiência Profissional e Time Qualificado
Fabricação e comercialização de insumos para microbiologia, como meios de cultura para crescimento de microrganismos.
Microbiologia
Desenvolvimento de meios de cultura
Preparações químicas em laboratórios fornecendo nutrientes para o crescimento de microrganismos como fungos e bactérias.

Insumos para microbiologia de qualidade
Fabricamos e comercializamos meios de cultura para microbiologia, fornecendo nutrientes essenciais para o crescimento de microrganismos como fungos e bactérias.


???
20
anos é a soma de experiência dos nossos profissionais na biomedicina.
????????
????????????????


